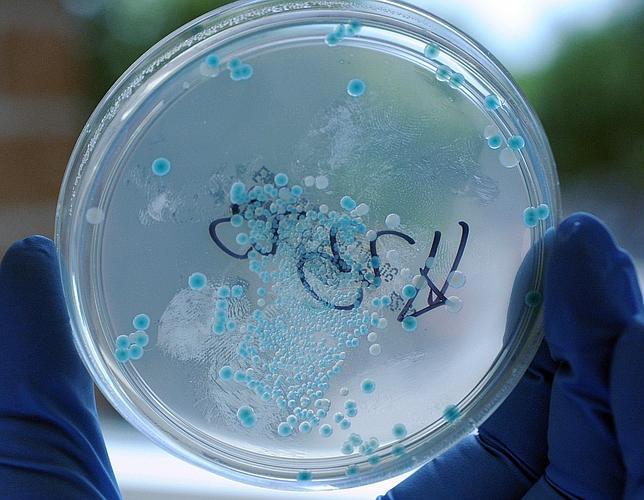
Reescriben el alfabeto de la vida

Reescriben el alfabeto de la vida
Científicos del Instituto Scripps (EE.UU.) crean el primer organismo vivo con tres pares de bases de ADN en lugar de los dos naturales
N. RAMÍREZ DE CASTRO
Al igual que el lenguaje se basa en una secuencia de letras cuyo orden da forma a las palabras, la vida también tiene su propio alfabeto genético. El alfabeto del ADN y de todas las formas de vida conocidas se escribe solo con cuatro «letras» ( ... A,T,G,C ) combinadas en dos pares de bases (A-T y C-G) y su secuencia o combinación determina su significado, es decir la función de las proteínas y los genes.
Los organismos vivos que pueblan la Tierra (humanos, plantas, bacterias, hongos, animales....) tienen en su material genético solo esas cuatro letras o dos pares de bases escritas a lo largo de la evolución. Ahora, por primera vez, científicos del Instituto de Investigación Scripps de California (EE.UU.) han reescrito el genoma de un ser vivo al añadir a su ADN un par de «letras» adicionales que no se encuentran en la Naturaleza.
Ese nuevo par de bases artificial han sido bautizadas por el Instituto Scripps como d5SICSTP-dNaMPT, una combinación de letras casi imposible de recordar. Una vez generadas se incorporaron a una pequeña parte del genoma de una bacteria y esta la aceptó sin problema, sin reconocerlo como una anomalía. Es decir la bacteria con seis «letras» en su código genético funcionó con normalidad. Así demostraron los investigadores que podía ampliarse el alfabeto de la vida.
Bacteria semisintética
El resultado de este experimento es un organismo semi-sintético que nunca había existido antes. «Contiene de manera estable tres pares de bases. Esto demuestra que hay otras soluciones posibles para almacenar la información genética y nos acerca a emocionantes aplicaciones, entre ellas el desarrollo de nuevos y más potentes medicamentos», augura el director de la investigación, Floyd Romesberg.
El avance, al que la revista «Nature» dedica su portada, es una prueba de concepto, un ejercicio experimental pero también supone un salto vertiginoso hacia la creación en el laboratorio de nuevos seres vivos, con genomas a la carta.
La creación de este «cyborg», este organismo semi-sintético se ha fabricado a partir de una bacteria muy conocida que puebla nuestro intestino, la «E. coli» . Es también una de las bacterias preferidas por los científicos para manipular por su sencillez y de ahí la elección del Instituto Scripps.
Dos décadas persiguiéndolo
El laboratorio de Romesberg llevaba más de dos décadas trabajando en esta línea, intentado fabricar los pares de moléculas que pudieran servir como bases de ADN y además fueran funcionales. Hasta ahora sus éxitos no habían pasado del tubo de ensayo. El gran reto que tenían era conseguir que esas pares de bases artificiales funcionaran en una célula viva y eso es lo que ahora han logrado.
La maquinaria celular de la bacteria no mostró cambios significativos al introducir las nuevas letras en el alfabeto de la vida. «Es como si en un libro escrito en castellano hubieran cambiado la letra «a» por la letra «alfa». Aunque nos pareciera raro al principio, seguro que no tendríamos problemas para leerlo. La maquinaria celular actúa como cualquier lector y aunque le moleste o note algo raro puede seguir leyendo», aclara a ABC Manuel Porcar, coordinador del grupo de Biología Sintética del Instituto Cavanilles de la Universidad de Valencia.
Hacia la creación de seres vivos a la carta
Con este nuevo paso la Ciencia se acerca un poco más a la ansiada creación de vida artificial. El primero en emprender el camino fue Craig Venter hace cuatro años al generar la primera célula portadora de un cromosoma sintético. A finales del mes de marzo se creó en el laboratorio un cromosoma de la levadura también generado de forma artificial, con procedimientos bioquímicos. Este ejercicio del Instituto Scripps también sigue la misma senda aunque sin copiar fielmente a la Naturaleza.
Fantaseando hasta podría pensarse en un futuro en la creación de un mundo paralelo, apunta Porcar. «En ese mundo convivirían los organismos vivos que hoy habitan la Tierra con otros creados en el laboratorio con otro código genético y a la medida de nuestras necesidades». La ventaja de crear estos organismos con ADN diferentes al nuestro es que serían «potencialmente más seguros» porque no se podrían reproducir y mezclar con otros seres vivos de la Naturaleza, asegura.
Sin embargo, deja claro que aún queda mucho tiempo para que veamos los resultados de esta parte de la biología sintética que empieza a llamarse «xenobiología».
Nuevos medicamentos
¿Y todo esto para qué sirve? Tanto este último avance como los otros progresos se enmarcan dentro de la biología sintética. Una disciplina joven que permite imaginar un futuro, aún lejano, en el que se podrán modificar organismos vivos según nuestro interés. Por ejemplo, crear bacterias artificiales que mejoren su capacidad para generar electricidad, suministrar biocombustibles para acabar con la dependencia del petróleo o desarrollar medicamentos más potentes y completamente nuevos.
Código genético alternativo
Este nuevo paso que se acaba de dar es «un avance fantástico» para Rafael Giraldo, del Centro de Investigaciones Biológicas del CSIC. Además de las potenciales aplicaciones prácticas, este experto en biología sintética resalta el avance conceptual que supone. «Por primera vez se ha demostrado que un código genético alternativo funciona “in vivo”. En un futuro podremos diseñar códigos genéticos a la carta».
El catedrático de Microbiología César Nombela valora el «virtuosismo» que ha demostrado el equipo de Romesberg, aunque rebaja el entusiasmo. «La biología sintética todavía ha de recorrer caminos basados en el diseño de nuevos organismos combinando los genes existentes, de ahí se han de derivar los resultados y aplicaciones novedosas que aún estamos esperando».
Un abismo en la evolución de la vida
La revista «Nature» recoge las opiniones de otros expertos. «Es posible que, con el tiempo, la maquinaria celular adopte las dos bases artificiales como parte de su propio alfabeto genético», señalan Jared Ellefson y Ross Thyer, del Centro de Biología Sintética y de Sistemas de la Universidad de Texas en Austin. «Si así fuera se abriría un nuevo campo en el que la ingeniería humana podría saltar sobre un abismo que había sido insondable para la evolución de la vida», escriben.
.
Reescriben el alfabeto de la vida
Esta funcionalidad es sólo para suscriptores
Suscribete
Esta funcionalidad es sólo para registrados
Iniciar sesiónEsta funcionalidad es sólo para suscriptores
Suscribete